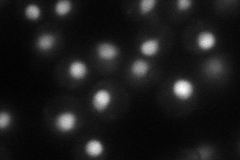
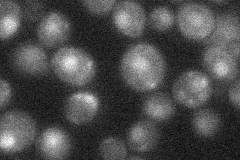
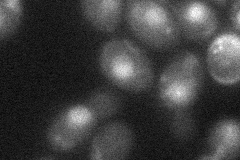
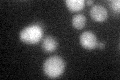

View description
Protein kinase, required for cell-cycle arrest in response to DNA damage; activated by trans autophosphorylation when interacting with hyperphosphorylated Rad9p; also interacts with ARS1 and plays a role in initiation of DNA replication
Localization:
Intensity:
Fold change:
Significance:
-
C’ GFP library in SD

below threshold15.24 -
N' NOP1pr-GFP in SD
nucleus53.6998 -
N' TEF2pr-mCherry in SD

nucleus53.1991 -
N' NATIVEpr-GFP in SD
nucleus25.1231 -
N' TEF2pr-VC and Cyto-VN in SD
nucleus30.1934 -
C’ GFP library in SD+DTT
cytosol17.211.12No -
C’ GFP library in SD+H2O2

cytosol15.120.99No -
C’ GFP library in Starvation Media

cytosol16.391.07No -
C’ GFP library on the background of Pup2-DaMP

below threshold -
C’ GFP library on the background of CCT mutant

below threshold15.82111.03766No
